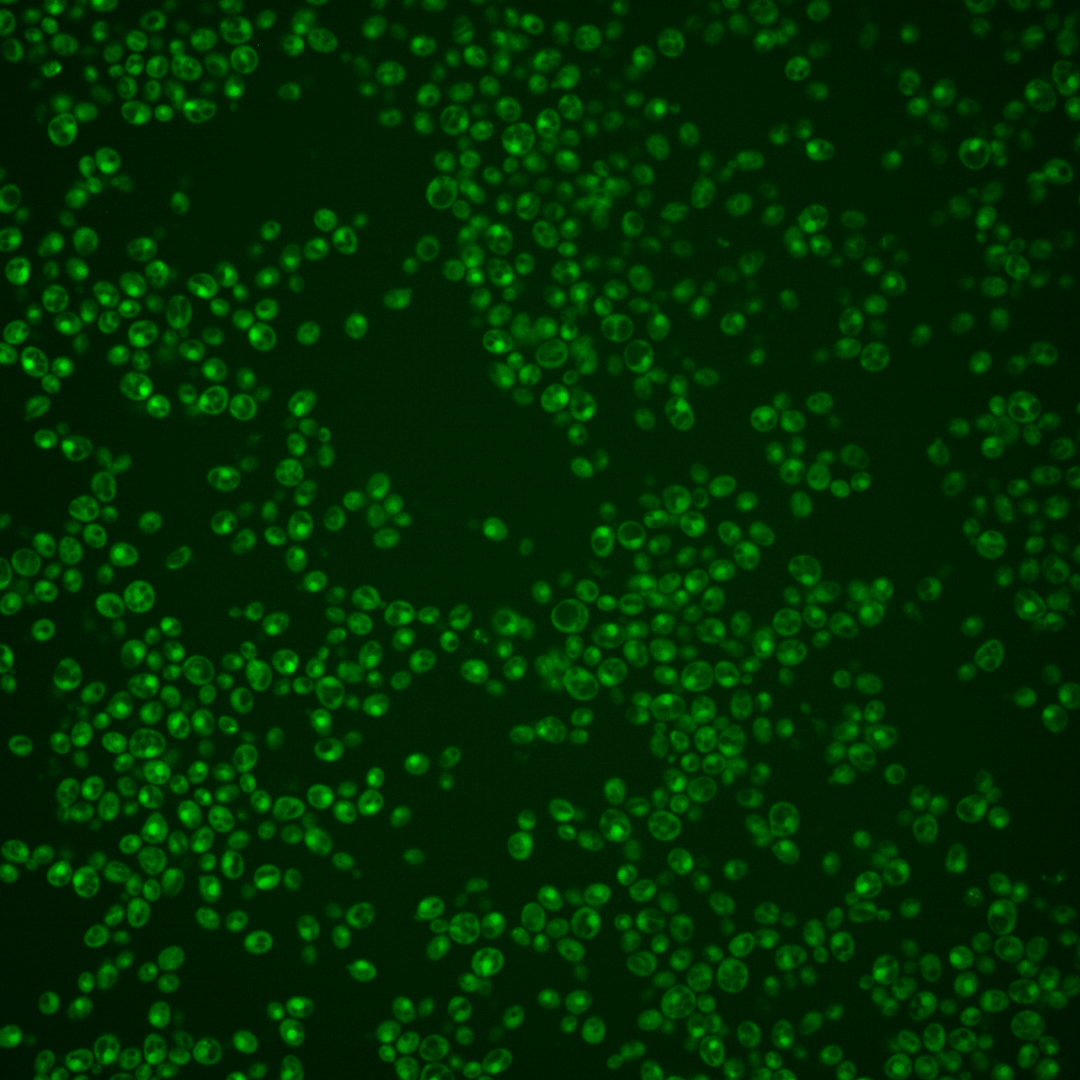
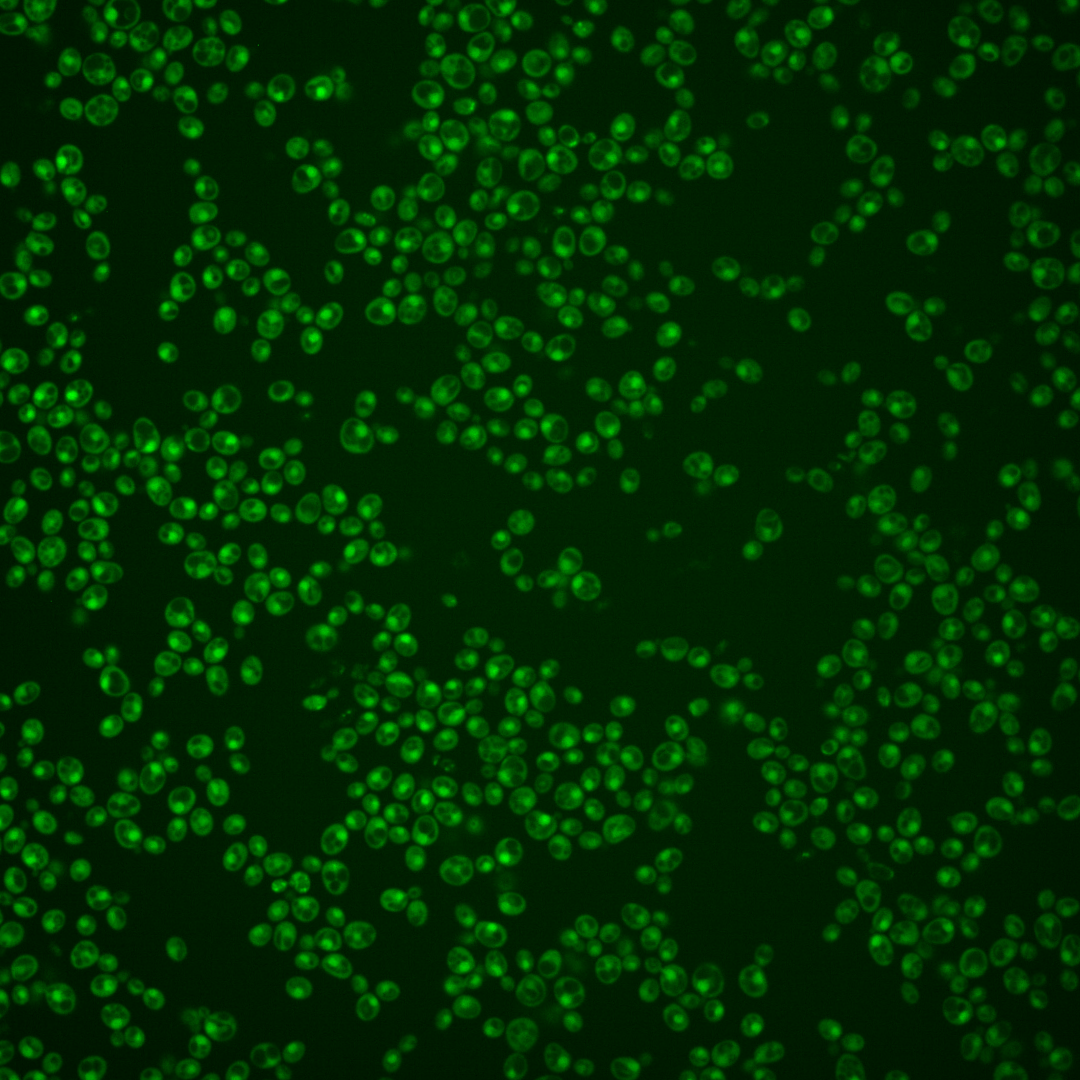
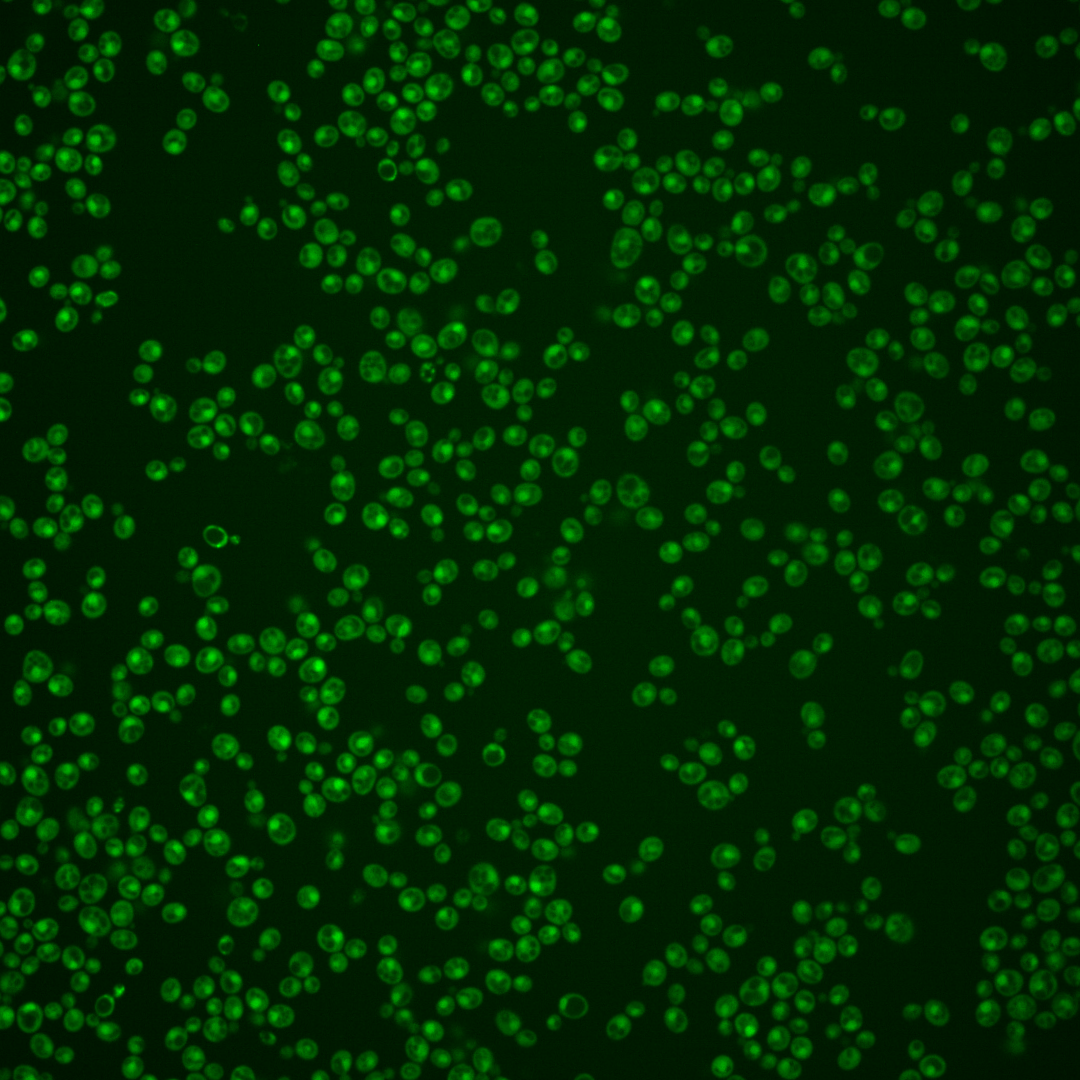
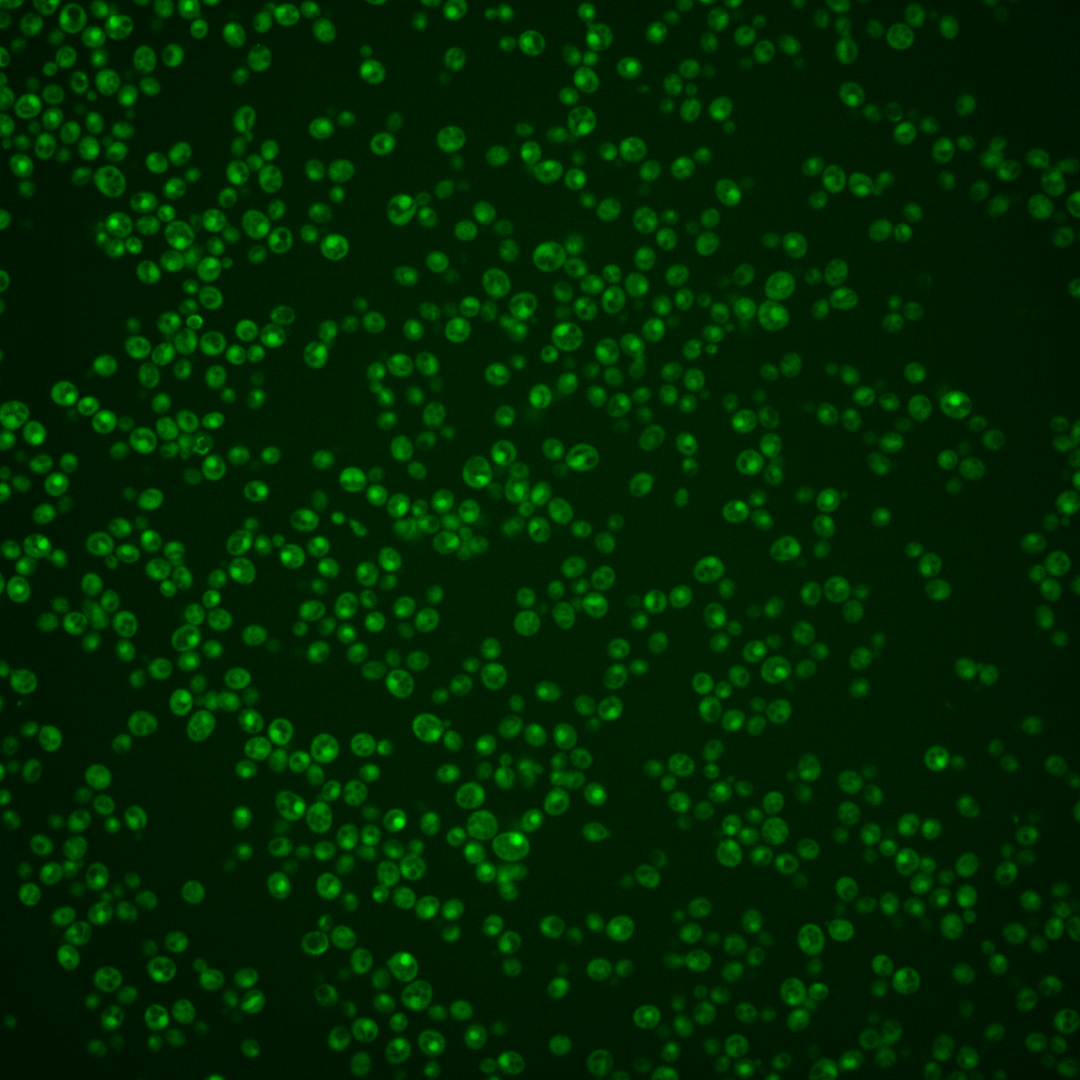
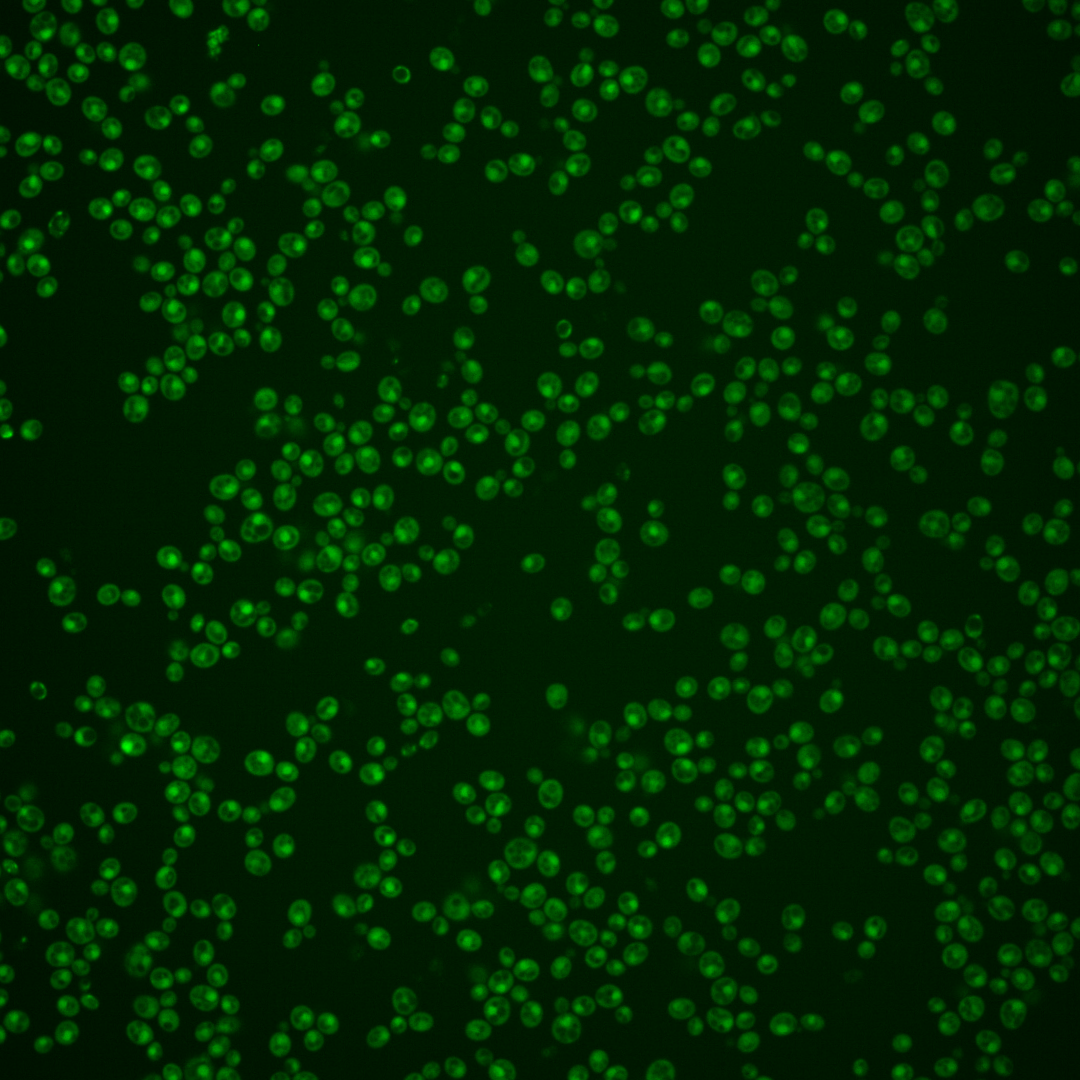
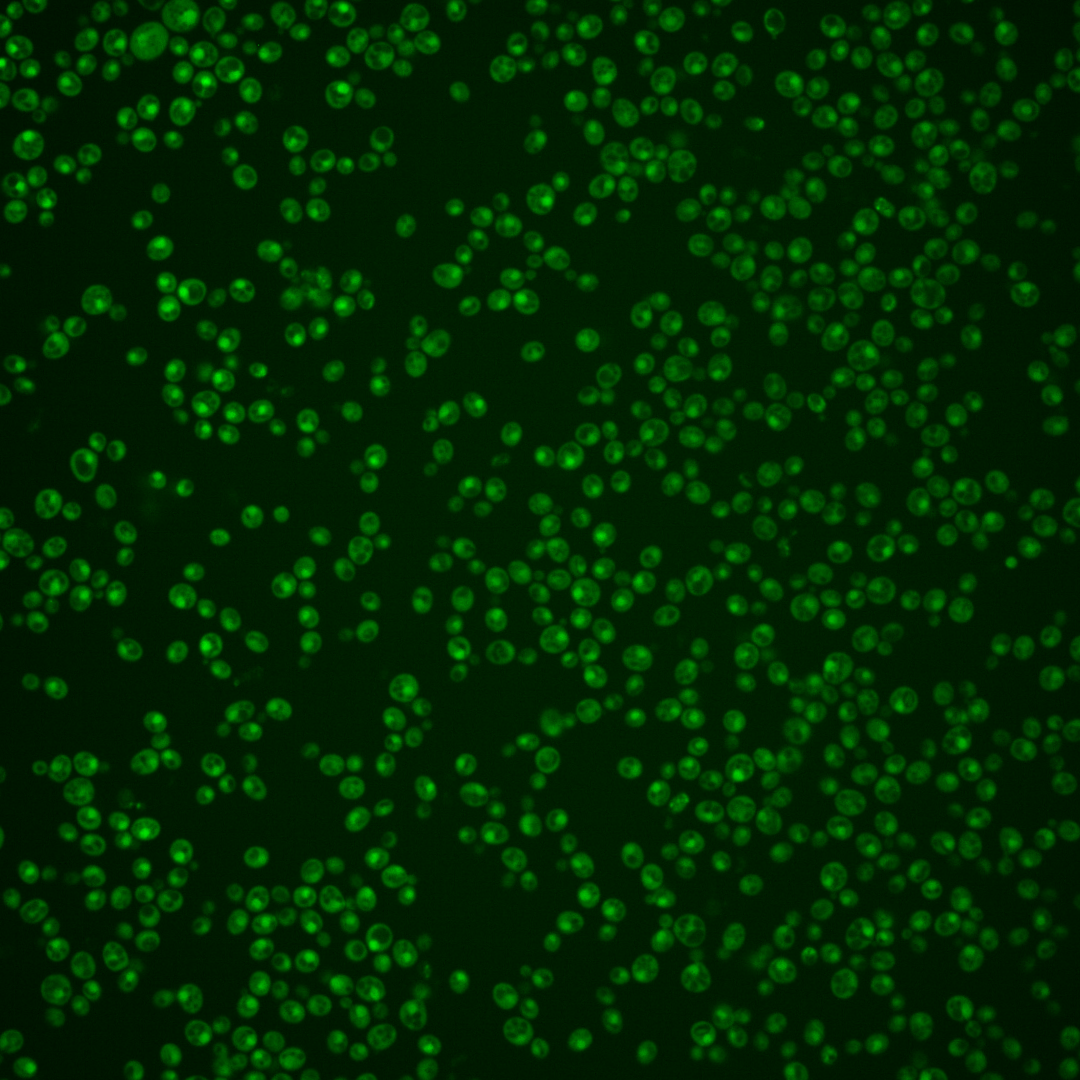

| Standard name | |
|---|---|
| Human Ortholog | |
| Description | Putative protein of unknown function; non-essential gene identified in a screen for mutants with increased levels of rDNA transcription; weak similarity with uridine kinases and with phosphoribokinases |
Micrographs




















































































Sub-cellular Localization
Yeast GFP Assignment
Protein Abundance
Localization Change
External localization resources
| ensLOC | DeepLoc | |||||||||||||||||||||||
|---|---|---|---|---|---|---|---|---|---|---|---|---|---|---|---|---|---|---|---|---|---|---|---|---|
| Localization | WT1 | WT2 | WT3 | RAP60 | RAP140 | RAP220 | RAP300 | RAP380 | RAP460 | RAP540 | RAP620 | RAP700 | HU80 | HU120 | HU160 | rpd3Δ_1 | rpd3Δ_2 | rpd3Δ_3 | WT1 | WT2 | WT3 | AF100 | AF140 | AF180 |
| Cortical Patches | 0 | 0 | 0 | 0 | 1 | 0 | 0 | 0 | 1 | 0 | 1 | 0 | 0 | 0 | 0 | 0 | 0 | 0 | 0 | 0 | 0 | 0 | 0 | 2 |
| Bud | 0 | 0 | 0 | 0 | 0 | 5 | 0 | 0 | 5 | 2 | 14 | 4 | 0 | 0 | 0 | 0 | 0 | 0 | 10 | 12 | 5 | 10 | 15 | 19 |
| Bud Neck | 0 | 0 | 0 | 0 | 0 | 0 | 0 | 0 | 0 | 0 | 0 | 0 | 0 | 0 | 0 | 0 | 0 | 0 | 0 | 1 | 1 | 1 | 2 | 5 |
| Bud Site | 0 | 0 | 0 | 0 | 0 | 0 | 0 | 0 | 0 | 1 | 1 | 0 | 0 | 0 | 0 | 0 | 0 | 0 | – | – | – | – | – | – |
| Cell Periphery | 0 | 0 | 0 | 1 | 1 | 0 | 1 | 4 | 0 | 3 | 3 | 7 | 0 | 0 | 0 | 2 | 0 | 1 | 0 | 0 | 0 | 0 | 0 | 0 |
| Cytoplasm | 104 | 116 | 66 | 71 | 82 | 84 | 145 | 167 | 166 | 235 | 154 | 220 | 81 | 131 | 131 | 40 | 62 | 25 | 50 | 61 | 49 | 85 | 80 | 64 |
| Endoplasmic Reticulum | 5 | 0 | 1 | 0 | 0 | 0 | 0 | 0 | 1 | 0 | 1 | 0 | 2 | 0 | 0 | 4 | 2 | 5 | 1 | 0 | 1 | 3 | 1 | 3 |
| Endosome | 2 | 2 | 5 | 7 | 6 | 0 | 3 | 7 | 9 | 6 | 17 | 4 | 7 | 2 | 12 | 6 | 4 | 3 | 8 | 7 | 7 | 15 | 17 | 18 |
| Golgi | 1 | 0 | 0 | 0 | 0 | 0 | 0 | 1 | 0 | 0 | 0 | 0 | 0 | 1 | 0 | 0 | 0 | 0 | 2 | 4 | 1 | 1 | 2 | 2 |
| Mitochondria | 1 | 3 | 0 | 0 | 2 | 57 | 18 | 40 | 75 | 78 | 153 | 118 | 0 | 2 | 0 | 8 | 4 | 1 | 3 | 0 | 4 | 0 | 3 | 4 |
| Nucleus | 75 | 54 | 105 | 100 | 61 | 31 | 70 | 68 | 49 | 59 | 54 | 52 | 54 | 74 | 84 | 16 | 16 | 6 | 173 | 183 | 151 | 157 | 159 | 132 |
| Nuclear Periphery | 1 | 0 | 0 | 0 | 0 | 0 | 0 | 0 | 0 | 0 | 0 | 1 | 0 | 0 | 0 | 0 | 0 | 0 | 2 | 1 | 1 | 2 | 2 | 4 |
| Nucleolus | 0 | 0 | 0 | 0 | 0 | 0 | 0 | 1 | 0 | 0 | 0 | 0 | 0 | 0 | 0 | 0 | 0 | 1 | 2 | 3 | 2 | 5 | 7 | 5 |
| Peroxisomes | 0 | 0 | 0 | 0 | 0 | 0 | 0 | 0 | 0 | 0 | 0 | 0 | 0 | 0 | 0 | 0 | 0 | 0 | 0 | 0 | 0 | 0 | 0 | 0 |
| SpindlePole | 0 | 0 | 0 | 0 | 0 | 0 | 0 | 0 | 0 | 0 | 0 | 0 | 0 | 0 | 0 | 0 | 0 | 0 | 7 | 6 | 8 | 11 | 14 | 16 |
| Vac/Vac Membrane | 152 | 196 | 96 | 109 | 98 | 58 | 113 | 131 | 145 | 151 | 132 | 158 | 129 | 145 | 154 | 70 | 41 | 53 | 16 | 35 | 20 | 42 | 48 | 44 |
| Unique Cell Count | 255 | 299 | 223 | 261 | 220 | 199 | 302 | 365 | 379 | 460 | 417 | 487 | 241 | 317 | 337 | 122 | 105 | 77 | 284 | 320 | 257 | 343 | 362 | 332 |
| Labelled Cell Count | 341 | 371 | 273 | 288 | 251 | 235 | 350 | 419 | 451 | 535 | 530 | 564 | 273 | 355 | 381 | 146 | 129 | 95 | 284 | 320 | 257 | 343 | 362 | 332 |
Yeast GFP Assignment
Protein Abundance
| Screen | WT1 | WT2 | WT3 | RAP60 | RAP140 | RAP220 | RAP300 | RAP380 | RAP460 | RAP540 | RAP620 | RAP700 | HU80 | HU120 | HU160 | rpd3Δ_1 | rpd3Δ_2 | rpd3Δ_3 | AF100 | AF140 | AF180 |
|---|---|---|---|---|---|---|---|---|---|---|---|---|---|---|---|---|---|---|---|---|---|
| Mean Cell GFP Intensity (1e-4) | 8.3 | 8.7 | 8.5 | 8.2 | 8.5 | 5.4 | 7.2 | 6.7 | 6.2 | 6.2 | 6.0 | 6.4 | 8.3 | 8.3 | 8.5 | 11.4 | 10.9 | 11.0 | 8.1 | 8.2 | 8.8 |
| Std Deviation (1e-4) | 1.2 | 1.3 | 1.1 | 1.6 | 2.1 | 1.4 | 1.7 | 1.2 | 1.3 | 1.0 | 1.0 | 1.1 | 1.3 | 1.4 | 1.4 | 2.4 | 2.5 | 3.0 | 1.2 | 1.4 | 2.5 |
| Intensity Change (Log2) | – | – | – | -0.06 | 0.01 | -0.66 | -0.24 | -0.35 | -0.44 | -0.44 | -0.51 | -0.42 | -0.03 | -0.04 | -0.0 | 0.42 | 0.36 | 0.37 | -0.07 | -0.04 | 0.06 |
Localization Change
| Localization | RAP60 | RAP140 | RAP220 | RAP300 | RAP380 | RAP460 | RAP540 | RAP620 | RAP700 | HU80 | HU120 | HU160 | rpd3Δ_1 | rpd3Δ_2 | rpd3Δ_3 |
|---|---|---|---|---|---|---|---|---|---|---|---|---|---|---|---|
| Cortical Patches | 0 | 0 | 0 | 0 | 0 | 0 | 0 | 0 | 0 | 0 | 0 | 0 | 0 | 0 | 0 |
| Bud | 0 | 0 | 0 | 0 | 0 | 0 | 0 | 0 | 0 | 0 | 0 | 0 | 0 | 0 | 0 |
| Bud Neck | 0 | 0 | 0 | 0 | 0 | 0 | 0 | 0 | 0 | 0 | 0 | 0 | 0 | 0 | 0 |
| Bud Site | 0 | 0 | 0 | 0 | 0 | 0 | 0 | 0 | 0 | 0 | 0 | 0 | 0 | 0 | 0 |
| Cell Periphery | 0 | 0 | 0 | 0 | 0 | 0 | 0 | 0 | 0 | 0 | 0 | 0 | 0 | 0 | 0 |
| Cytoplasm | -0.6 | 1.7 | 2.7 | 4.3 | 3.9 | 3.5 | 5.3 | 1.9 | 3.9 | 0.9 | 2.8 | 2.3 | 0.6 | 5.1 | 0.5 |
| Endoplasmic Reticulum | 0 | 0 | 0 | 0 | 0 | 0 | 0 | 0 | 0 | 0 | 0 | 0 | 0 | 0 | 0 |
| Endosome | 0.3 | 0.3 | 0 | 0 | 0 | 0.1 | 0 | 1.2 | 0 | 0.4 | 0 | 0.9 | 0 | 0 | 0 |
| Golgi | 0 | 0 | 0 | 0 | 0 | 0 | 0 | 0 | 0 | 0 | 0 | 0 | 0 | 0 | 0 |
| Mitochondria | 0 | 0 | 8.6 | 3.7 | 5.1 | 7.1 | 6.5 | 10.4 | 8.1 | 0 | 0 | 0 | 0 | 0 | 0 |
| Nucleus | -1.9 | -4.2 | -6.9 | -5.7 | -7.3 | -9.3 | -9.8 | -9.5 | -10.8 | -5.6 | -5.8 | -5.4 | -6.3 | -5.6 | -6.2 |
| Nuclear Periphery | 0 | 0 | 0 | 0 | 0 | 0 | 0 | 0 | 0 | 0 | 0 | 0 | 0 | 0 | 0 |
| Nucleolus | 0 | 0 | 0 | 0 | 0 | 0 | 0 | 0 | 0 | 0 | 0 | 0 | 0 | 0 | 0 |
| Peroxisomes | 0 | 0 | 0 | 0 | 0 | 0 | 0 | 0 | 0 | 0 | 0 | 0 | 0 | 0 | 0 |
| SpindlePole | 0 | 0 | 0 | 0 | 0 | 0 | 0 | 0 | 0 | 0 | 0 | 0 | 0 | 0 | 0 |
| Vacuole | -0.3 | 0.3 | -3.0 | -1.3 | -1.7 | -1.2 | -2.6 | -2.9 | -2.7 | 2.3 | 0.6 | 0.6 | 2.5 | -0.7 | 3.9 |
External localization resources
Images






























Protein Concentration and Protein Localization Data
| R1 | R2 | R3 | ||||||||||||||||
|---|---|---|---|---|---|---|---|---|---|---|---|---|---|---|---|---|---|---|
| G1 Pre-START | G1 Post-START | S/G2 | Metaphase | Anaphase | Telophase | G1 Pre-START | G1 Post-START | S/G2 | Metaphase | Anaphase | Telophase | G1 Pre-START | G1 Post-START | S/G2 | Metaphase | Anaphase | Telophase | |
| Concentration | 2.2181 | 2.9683 | 2.5022 | 2.55 | 2.314 | 2.6836 | 3.8042 | 5.5575 | 4.8928 | 4.3071 | 4.1667 | 4.6126 | 6.0239 | 7.1769 | 6.2936 | 6.6708 | 5.6855 | 6.6632 |
| Actin | 0.0277 | 0.0001 | 0.0488 | 0.012 | 0.0524 | 0.0004 | 0.0324 | 0.0001 | 0.0193 | 0.0006 | 0 | 0.0005 | 0.007 | 0.0001 | 0.0026 | 0.0296 | 0 | 0.0088 |
| Bud | 0.0017 | 0.0001 | 0.0008 | 0.0004 | 0.0007 | 0.0005 | 0.0014 | 0.0004 | 0.0003 | 0.0004 | 0.0001 | 0.0001 | 0.0001 | 0.0001 | 0.0002 | 0.0001 | 0.0001 | 0.0003 |
| Bud Neck | 0.0012 | 0.0003 | 0.0037 | 0.0011 | 0.0017 | 0.0024 | 0.0063 | 0.0003 | 0.0005 | 0.0012 | 0.0007 | 0.0016 | 0.0004 | 0.0003 | 0.0011 | 0.0004 | 0.0005 | 0.0033 |
| Bud Periphery | 0.0015 | 0 | 0.0009 | 0.0004 | 0.0014 | 0.0009 | 0.0039 | 0.0001 | 0.0004 | 0.0003 | 0 | 0.0001 | 0.0001 | 0 | 0.0001 | 0.0001 | 0 | 0.0002 |
| Bud Site | 0.0026 | 0.0005 | 0.005 | 0.0051 | 0.0013 | 0.0003 | 0.0025 | 0.0007 | 0.0013 | 0.0084 | 0.0002 | 0.0002 | 0.0004 | 0.0005 | 0.0017 | 0.0002 | 0.0001 | 0.0003 |
| Cell Periphery | 0.0002 | 0 | 0.0003 | 0.0002 | 0.0003 | 0 | 0.0008 | 0 | 0.0001 | 0.0001 | 0 | 0 | 0 | 0 | 0.0001 | 0 | 0 | 0 |
| Cytoplasm | 0.0448 | 0.0611 | 0.0645 | 0.0502 | 0.0231 | 0.0335 | 0.0543 | 0.0604 | 0.0309 | 0.0186 | 0.0147 | 0.0249 | 0.0385 | 0.1043 | 0.0352 | 0.0208 | 0.0195 | 0.048 |
| Cytoplasmic Foci | 0.0245 | 0.0003 | 0.0065 | 0.0081 | 0.0066 | 0.0002 | 0.0129 | 0.0008 | 0.0146 | 0.0097 | 0.0001 | 0.0009 | 0.0024 | 0.0008 | 0.0046 | 0.0007 | 0.0001 | 0.0012 |
| Eisosomes | 0.0002 | 0 | 0.0002 | 0.0001 | 0.0006 | 0 | 0.0003 | 0 | 0.0002 | 0 | 0 | 0 | 0.0001 | 0 | 0 | 0.0002 | 0 | 0 |
| Endoplasmic Reticulum | 0.0121 | 0.0007 | 0.0049 | 0.0032 | 0.0042 | 0.0008 | 0.0147 | 0.0006 | 0.0041 | 0.0005 | 0.0004 | 0.0007 | 0.0028 | 0.003 | 0.0005 | 0.0021 | 0.0003 | 0.0009 |
| Endosome | 0.0381 | 0.0004 | 0.0201 | 0.0175 | 0.074 | 0.001 | 0.0418 | 0.0005 | 0.0179 | 0.007 | 0.0004 | 0.0015 | 0.0059 | 0.0017 | 0.0019 | 0.0022 | 0.0002 | 0.0014 |
| Golgi | 0.0086 | 0 | 0.0145 | 0.0258 | 0.0372 | 0.0001 | 0.0152 | 0 | 0.0049 | 0.0023 | 0 | 0.0003 | 0.002 | 0.0001 | 0.0011 | 0.0011 | 0 | 0.0003 |
| Lipid Particles | 0.0139 | 0 | 0.0021 | 0.0066 | 0.0351 | 0 | 0.0127 | 0 | 0.0013 | 0.0112 | 0 | 0.0007 | 0.0075 | 0.0001 | 0.0039 | 0.0006 | 0 | 0.0001 |
| Mitochondria | 0.009 | 0.0002 | 0.0052 | 0.01 | 0.0414 | 0.0008 | 0.0417 | 0.0003 | 0.0093 | 0.0017 | 0.0001 | 0.0046 | 0.0006 | 0.0002 | 0.0005 | 0.0003 | 0.0002 | 0.0004 |
| None | 0.0129 | 0.0033 | 0.0152 | 0.0025 | 0.0856 | 0.0004 | 0.0051 | 0.0005 | 0.002 | 0.0007 | 0.0003 | 0.0019 | 0.0115 | 0.0038 | 0.0093 | 0.0023 | 0.0004 | 0.0024 |
| Nuclear Periphery | 0.0567 | 0.0137 | 0.0143 | 0.0122 | 0.0248 | 0.008 | 0.0447 | 0.0099 | 0.0118 | 0.0066 | 0.0096 | 0.0108 | 0.0145 | 0.0084 | 0.0059 | 0.0088 | 0.0054 | 0.0076 |
| Nucleolus | 0.0027 | 0.0013 | 0.0015 | 0.0015 | 0.0012 | 0.003 | 0.0104 | 0.0016 | 0.001 | 0.0034 | 0.0018 | 0.0021 | 0.0012 | 0.0011 | 0.0031 | 0.0006 | 0.0013 | 0.0019 |
| Nucleus | 0.7045 | 0.9119 | 0.7735 | 0.8297 | 0.5861 | 0.9442 | 0.658 | 0.9145 | 0.8725 | 0.8748 | 0.9663 | 0.9407 | 0.8977 | 0.8709 | 0.9212 | 0.9267 | 0.9686 | 0.9138 |
| Peroxisomes | 0.011 | 0 | 0.0034 | 0.0015 | 0.0061 | 0 | 0.0095 | 0 | 0.0024 | 0.0035 | 0 | 0.0002 | 0.0018 | 0 | 0.0027 | 0.0004 | 0 | 0.0009 |
| Punctate Nuclear | 0.0148 | 0.005 | 0.0124 | 0.0098 | 0.0049 | 0.0018 | 0.0142 | 0.0082 | 0.003 | 0.0468 | 0.0049 | 0.007 | 0.0046 | 0.0035 | 0.0032 | 0.0024 | 0.003 | 0.0074 |
| Vacuole | 0.0059 | 0.0009 | 0.0017 | 0.0012 | 0.0065 | 0.0014 | 0.012 | 0.0008 | 0.0014 | 0.0017 | 0.0004 | 0.0008 | 0.0007 | 0.001 | 0.0009 | 0.0002 | 0.0003 | 0.0008 |
| Vacuole Periphery | 0.0053 | 0.0002 | 0.0007 | 0.0009 | 0.0046 | 0.0003 | 0.0052 | 0.0001 | 0.0008 | 0.0003 | 0.0001 | 0.0003 | 0.0003 | 0.0001 | 0.0002 | 0.0001 | 0.0001 | 0.0002 |
Sequencing Data
| R1 | R2 | |||||||||
|---|---|---|---|---|---|---|---|---|---|---|
| G1 Post-START | S/G2 | Metaphase | Anaphase | Telophase | G1 Post-START | S/G2 | Metaphase | Anaphase | Telophase | |
| Gene Expression | 14.9962 | 19.7557 | 13.6125 | 10.4237 | 9.2099 | 7.8884 | 9.2741 | 9.6298 | 10.8074 | 13.176 |
| Translational Efficiency | 1.019 | 0.6517 | 0.9042 | 1.0238 | 1.0832 | 1.3189 | 1.7924 | 1.1141 | 0.8211 | 1.1617 |
Hit Data
| Dataset | Hit |
|---|---|
| Protein Concentration | ✘ |
| Protein Localization | ✘ |
| Gene Expression | ✘ |
| Translational Efficiency | ✘ |
Endocytosis
| Temp | Actin Patch (Sac6-tdTomato) | Cortical Patch (Sla1-GFP) | Late Endosome (Snf7-GFP) | Vacuole (Vph1-GFP) |
|---|---|---|---|---|
| 37℃ | ||||
| RT |
Cell Cycle Omics
CYCLoPs (Das2-GFP)
| Gene / Allele | Actin Patch (Sac6-tdTomato) | Cortical Patch (Sla1-GFP) | Late Endosome (Snf7-GFP) | Vacuole (Sac6-tdTomato) |
|---|
| Gene | Images |
|---|
| Gene | Images |
|---|
Images are not yet available
Images are not yet available